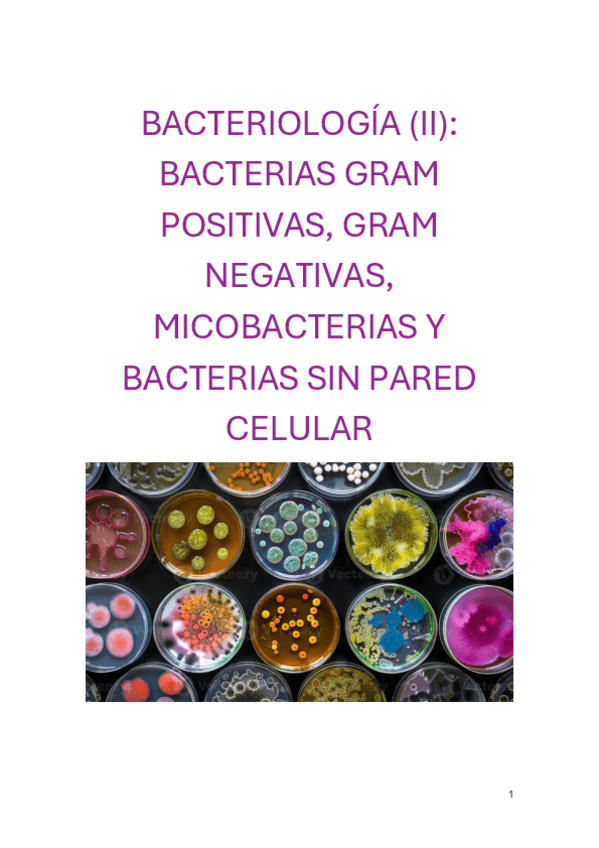

Microbiología, parasitología e Inmunología Humana
apuntes
-
Tablas bacterias
He publicado nuevos apuntes de 3º Microbiología, parasitología e Inmunología Humana: Tablas bacterias
Primer cuatri de Micro (bacterias). Transcripción de las clases de alba con comparaciones del Murray (año 2023). Tercera parte
Primer cuatri de Micro (bacterias). Transcripción de las clases de alba con comparaciones del Murray (año 2023). Segunda parte
Primer cuatri de Micro (bacterias). Transcripción de las clases de alba con comparaciones del Murray (año 2023). Primera parte
Segundo cuatri (parásitos, hongos y virus). tercera parte
Segundo cuatri (parásitos, hongos y virus). cuarta parte
Segundo cuatri (parásitos, hongos y virus). Segunda parte
Segundo cuatri (parásitos, hongos y virus). Primera parte
apuntes
-
Dibujos 2º examen
Os dejo algunos dibujos con las cosas más importantes de los microorganismos del segundo examen. Ánimo que se saca!!
He publicado nuevos apuntes de 3º Microbiología, parasitología e Inmunología Humana: Tabla-Fasciolas-vs-Opistorchis-Clonorchis.png
He publicado nuevos apuntes de 3º Microbiología, parasitología e Inmunología Humana: Geohelmintos-General.png
He publicado nuevos apuntes de 3º Microbiología, parasitología e Inmunología Humana: Esquemas-todo-parasitos.pdf
apuntes
-
Todo bacterias
Desde Klebsiella, no están los primeros temas de introducción (antibióticos,microbiota…)
apuntes
-
HEPATITIS -VIH-SEROLOGÍAS
Resumen virus hepatitis-VIH y apuntes de las serologíass!!
He publicado nuevos apuntes de 3º Microbiología, parasitología e Inmunología Humana: Micosis-oportunistas.pdf
He publicado nuevos apuntes de 3º Microbiología, parasitología e Inmunología Humana: Leishmania-y-mas.pdf
He publicado nuevos apuntes de 3º Microbiología, parasitología e Inmunología Humana: Apicomplejos-hematicos-y-tisulares.pdf
He publicado nuevos apuntes de 3º Microbiología, parasitología e Inmunología Humana: Virus-exantematicos.pdf
He publicado nuevos apuntes de 3º Microbiología, parasitología e Inmunología Humana: FLASH-CARDS-vacunacion-del-viajero.pdf
He publicado nuevos apuntes de 3º Microbiología, parasitología e Inmunología Humana: Herpesvirus.pdf
He publicado nuevos apuntes de 3º Microbiología, parasitología e Inmunología Humana: Varios-Dx-preguntados.pdf
He publicado nuevos apuntes de 3º Microbiología, parasitología e Inmunología Humana: Parotiditis.pdf
He publicado nuevos apuntes de 3º Microbiología, parasitología e Inmunología Humana: Retrovirus.pdf
He publicado nuevos apuntes de 3º Microbiología, parasitología e Inmunología Humana: HepatitisAyE.pdf
He publicado nuevos apuntes de 3º Microbiología, parasitología e Inmunología Humana: HepatitisC.pdf
He publicado nuevos apuntes de 3º Microbiología, parasitología e Inmunología Humana: Arbovirus.pdf
He publicado nuevos apuntes de 3º Microbiología, parasitología e Inmunología Humana: HepatitisBandD.pdf
apuntes
-
TEORÍA HONGOS, PARÁSITOS Y VIRUS 25-26
He publicado nuevos apuntes de 3º Microbiología, parasitología e Inmunología Humana: TEORÍA HONGOS, PARÁSITOS Y VIRUS 25-26
He publicado nuevos apuntes de 3º Microbiología, parasitología e Inmunología Humana: Virus-respiratorios.pdf
He publicado nuevos apuntes de 3º Microbiología, parasitología e Inmunología Humana: Enterovirus.pdf
He publicado nuevos apuntes de 3º Microbiología, parasitología e Inmunología Humana: ViralGastroenteritisClinicalDossier.pdf
He publicado nuevos apuntes de 3º Microbiología, parasitología e Inmunología Humana: Virus-rabia.pdf
He publicado nuevos apuntes de 3º Microbiología, parasitología e Inmunología Humana: Filovirus.pdf
apuntes
-
Virus 2025/26
Algunos temas de virus que no están muy bien en los apuntes :)
practicas
-
PRÁCTICAS 25-26
He publicado nuevos practicas de 3º Microbiología, parasitología e Inmunología Humana: PRÁCTICAS 25-26
Créditos al usuario colofu_, por lo visto están borradas estas tablas así que resubo este lost media, suerte con los exámenes =)
Por lo visto están borrados de Wuolah, son lost media, así que los subo refritos =)
He publicado nuevos practicas de 3º Microbiología, parasitología e Inmunología Humana: Resumen-todas-vacunas-viajero-202526.pdf
apuntes
-
Apuntes virus
He publicado nuevos apuntes de 3º Microbiología, parasitología e Inmunología Humana: Apuntes virus
He publicado nuevos apuntes de 3º Microbiología, parasitología e Inmunología Humana: APUNTES-PRACTICAS-MICROBIOLOGIA.-Con-Fotos.pdf
apuntes
-
Dibujos Bacterias
He publicado nuevos apuntes de 3º Microbiología, parasitología e Inmunología Humana: Dibujos Bacterias
apuntes
-
Esquemas 3er parcial
He publicado nuevos apuntes de 3º Microbiología, parasitología e Inmunología Humana: Esquemas 3er parcial
apuntes
-
Trucos de todos los microorganismos del tercer examen. Mucha Suerte!
He publicado nuevos apuntes de 3º Microbiología, parasitología e Inmunología Humana: Trucos de todos los microorganismos del tercer examen. Mucha Suerte!
apuntes
-
VOCABULARIO Y TABLAS
Todos los diagnósticos para cada microorganismo junto a un vocabulario con las cosas más difíciles/específicas que uno suele olvidar.
apuntes
-
TEORÍA BACTERIAS 25-26
He publicado nuevos apuntes de 3º Microbiología, parasitología e Inmunología Humana: TEORÍA BACTERIAS 25-26
apuntes
-
Bacterias 25/26
He publicado nuevos apuntes de 3º Microbiología, parasitología e Inmunología Humana: Bacterias 25/26
He publicado nuevos apuntes de 3º Microbiología, parasitología e Inmunología Humana: TABLA-ANTIBIOTICOS.pdf
apuntes
-
Apuntes teoría microbiología
Os iré subiendo los apuntes de la parte de Alba. Primero para el segundo examen: una introducción y bacterias; finalmente os subiré la parte para el tercer examen. ¡Ánimo! Con estos apuntes saqué todo a la primera.
He publicado nuevos examenes de 3º Microbiología, parasitología e Inmunología Humana: PREGUNTAS-MICRO-POR-ANOS.pdf
apuntes
-
APUNTES BACTERIAS
He publicado nuevos apuntes de 3º Microbiología, parasitología e Inmunología Humana: APUNTES BACTERIAS